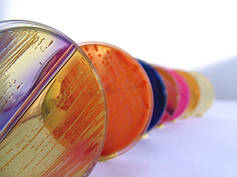
Поживні середовища

Хімічні реактиви
Всі фотографії є прикладом товару і можуть відрізнятися від реального зовнішнього вигляду, так само терміни і парія можуть змінюватися і відрізнятися.
У цьому розділі запропоновані хімічні реактиви, діагностичні тести, дезінфікуючі засоби та інші компоненти, без яких існування лабораторії неможливе. Усі представлені товари мають сертифікати якості. Ми ретельно стежимо за дотриманням правил зберігання реактивів та терміном придатності, тому ми маємо лише свіжі засоби високої якості.
Реактиви, діагностичні тести та дезинфікуючі засоби
У нас ви знайдете наступні товари:
● индикатори (купризон, люминор, тимор, азур и др.);
● стандарт-титри (для приготування стандартних розчинів за точною концентрацією);
● поживні середовища (агар, основа бульйону);
● дезінфікуючі засоби (для дезінфекції та передстерилізаційного очищення, санітарної обробки);
● діагностичні тести (сироватки, тест-смужки різного призначення);
● кислоти (хлорна кислота, бутилацетат, адипиновая кислота, карбід кальцію тощо).
Широкий вибір хімічних реактивів для лабораторних досліджень (6 груп товарів, більше 100 найменувань товарів).
Лабораторні хімічні засоби
Фахівці «Лабораторний маркет» пропонує допомогу своїм клієнтам на всіх етапах співпраці. Ми проводимо кваліфіковану консультацію по хімічних реактивів, при необхідності проводимо безкоштовне навчання, семінари та консультації для персоналу. Докладно розкриваємо питання підбору і використання лабораторних препаратів. Фахівці нашої компанії мають практичний досвід роботи в лабораторіях, знають особливості підбору дезінфекційних засобів та діагностичних тестів.
Отримати детальну консультацію можна за телефоном компанії або замовивши зворотній дзвінок. Зробити замовлення можна через корзину сайту або за допомогою телефонного дзвінка.
Фото служить прикладом, реактиви йдуть у поліетиленовій фасовці у замовленій кількості!
- 1 336 ₴В наявності
- 268 ₴/лВ наявності
- 1 400 ₴Під замовлення
- 450 ₴/кгПід замовлення
- 2 150 ₴/упаковкаПід замовлення
- 14 040 ₴/упаковкаВ наявності
- 70 ₴В наявності
- 135 ₴/упаковкаВ наявності
- 37 950 ₴/упаковкаВ наявності
- 312 ₴/упаковкаВ наявності
- 210 ₴/упаковкаВ наявності
- 149 ₴/упаковкаВ наявності
- 120 ₴В наявності
- 422 ₴/упаковкаВ наявності
- 250 ₴/упаковкаВ наявності
- 312 ₴/упаковкаВ наявності
- 2 300 ₴/упаковкаПід замовлення
- 4 290 ₴/упаковкаВ наявності
- 117 ₴/упаковкаВ наявності
- 4 049 ₴/кгВ наявності
- 1 950 ₴/упаковкаВ наявності
- 1 200 ₴/упаковкаВ наявності
- 273 ₴/упаковкаВ наявності
- 1 026 ₴/упаковкаВ наявності